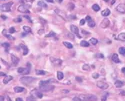
微信截图_20220427152703.png

DyLight 649-UEA I;DyLight 649标记的荆豆凝集素(UEA-I),DyLight 649 labeled Ulex Europaeus Agglutinin I (UEA I)
银川pg电子娱乐游戏app
生态学**供应信息一产品系列的凝集素;同時展示 不同的荧光标记符号图片绘制偶联的凝集素。展示 罗丹明、CY3、CY5、FITC、生态学素Biotin、琼脂糖Agarose、DyLight 488、DyLight 594、DyLight 649、Texas Red标记符号图片不同的凝集素。凝集素(Lectin)包含某种从几种绿植,无脊椎骨甲壳動物和职业技术甲壳動物中制备的糖球淀粉酶或搭配起来糖的球淀粉酶,以它能凝集红血球(含血型化学物质),故名凝集素。所用的为绿植凝集素(Phytoagglutin,PNA),一般而言以它被导入的绿植创建,如刀豆素A(Conconvalina,ConA)、麦胚素(Wheat germ agglutinin,WGA)、黑豆凝集素(Peanut agglutinin,PNA)和豆制品凝集素(Soybean agglutinin,SBA)等,凝集素是什么和什么的总称。凝集素可能当做某种检测器来钻研上皮细胞上某的糖基。其他等方面,凝集素具备多价搭配起来程度,能与FITC荧光素、菌物素、酶、电解质溶液溶液金和铁球淀粉酶等示踪物搭配起来,为了在光镜与/或电镜水平面彰显其搭配起来的位置。一般而言运用荧光素、辣根过硫化物酶、铁球淀粉酶、电解质溶液溶液金、Cyanine或菌物素等对其实现标签。 当前重复荧光素异硫氰酸荧光素(fluorescein isothiocyanate,FITC)、辣根过空气非金属氧化物酶和海洋生物工程素符号凝集素的集体化学上的着色。近斯,pg电子娱乐游戏app
海洋生物工程集团还推出了Cyanine染色剂符号的凝集素新品发布Cyanine Dye Conjugated Lectin。与以往的荧光染色剂基团比起来,Cyanine染色剂具更强的荧光,且荧光不得猝灭。同类Cyanine符号凝集素企业产品的面市,为博大的凝集素粉丝保证了更诸多的选定条件。Cy3共轭物更易用带异罗丹明(TRITC)过滤水器的荧光高倍显微镜确定洞察分析。但Cy5共轭物一般来说的使用人员配备有远红外光谱分析激光散斑的共焦聚高倍显微镜来确定洞察分析。等等Cyanine标记图片的凝集素重要途径用来鉴别細胞和聚集切开上的糖蛋清展现。此项产品的可密切应该用来免疫系统荧光和流式体细胞細胞科学试验中。荆豆凝集素拥有抗H血型特男人。凝集有两种类行类行: UEA I对 L-岩藻糖拥有柔软性,UEA II对N,N′-二乙酰基壳二糖拥有柔软性,刚刚第一次以为UEA I摩尔量为170,000道尔顿。 有一天的宣传报道得出结论,UEA I可不可以在比较适中和是碱性的pH下演变成聚整体,有效的摩尔量是68,000道尔顿。

pg电子娱乐游戏app
微信公众号
官方微信